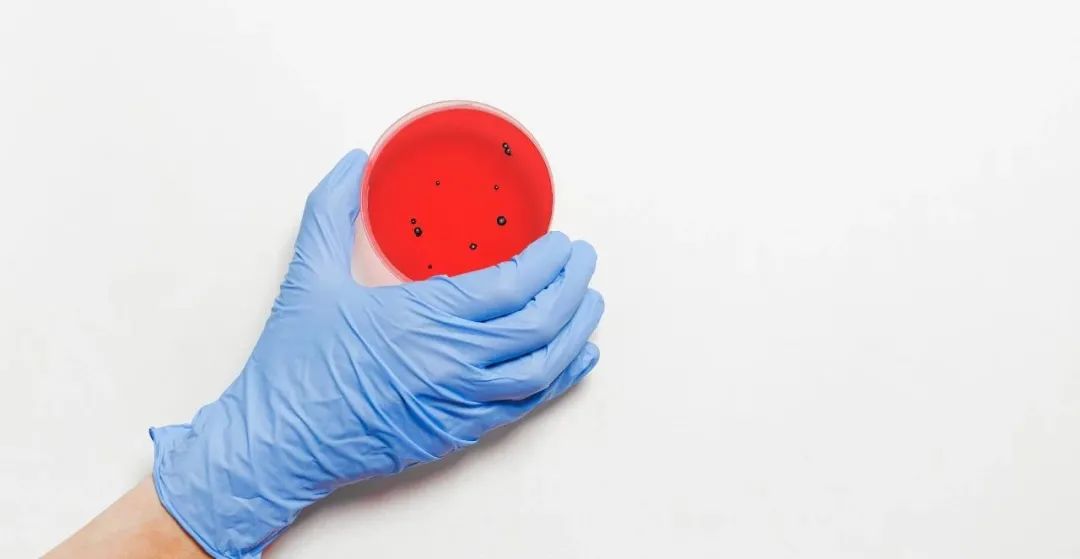
3715eb9e0d7cec99a91f07484b8b3c327e6cf98a.jpeg

如今,只要提到2020年,有兩個字似乎就會自動跳進很多人的腦袋:
魔幻。
百度百科有雲:魔幻是由個人或群體制造出來的包括有不是人但是帶有人性的形象行爲主體組成的虛構幻界。主要是用以此表現人的社會和觀念等。
好吧,說人話就是:驚奇、無語、創紀錄與“何似在人間”。
從開年的新冠疫情,到年底的美國大選,似乎每一件事都在向我們說明什麽叫做真正的魔幻。
小時候,想到2020年,只覺得會是個非常科幻的年份;親身經曆後,才發現這哪裏是什麽科幻,簡直魔幻。
那麽在如此魔幻的2020年,新加坡、中國乃至世界都發生了啥?
01.
新加坡的魔幻2020
老實講,新加坡的疫情沒什麽可說的,在全世界都爆發新冠疫情的時候,一個國家、一座城市的疫情實在不值得單拎出來說它魔幻。
真正魔幻的是新加坡疫情帶來的連鎖反應。
第一是“封城”,第二是客工宿舍,第三是經濟萎縮。
疫情來了,爲了控制持續蔓延的疫情,建國55周年的新加坡做出了許多“史無前例”的舉動。
“封城”就是其中一個。
病例一度暴漲,疫情眼看著就要失控,新加坡不得已只能選擇暫時關閉邊境,停下腳步,給全島按下了暫停鍵。
關閉邊境;關閉所有非必要工作場所;學校停課;落實居家辦公……
雖說之前在2003年SARS在新加坡爆發之時也有過這麽一場,但是這次的“封城”時間之久,涉及之廣,影響之大,真的是“史無前例”。
然後是客工宿舍。
事實上,客工問題一直是疫情在新加坡二次爆發以來最受國際輿論關注的點。
在疫情爆發初期,新加坡開展“佛系抗疫”,成爲全球抗疫典範,卻忽略了人口密度極大的客工宿舍。
四月開始,疫情開始在新加坡的客工宿舍肆虐,新加坡也隨之進入了抗疫緊急狀態。
之後,越來越多媒體開始關注新加坡客工群體生存環境的問題,客工們的真實境遇也被更多人所了解。
由于工作場所集中,勞動力密集,外籍勞工一般集中居住在爲他們特別建造的客工宿舍。宿舍裏的居住條件很擁擠,一個房間往往住有高達12名客工,共用廚房、廁所、洗衣間等公共設施。
由于條件簡陋、衛生狀況欠佳,這些宿舍可以說是新加坡的貧民窟,是新加坡這個第一世界國家的第三世界區域,一旦病毒潛入,就很容易發生大規模蔓延。
此外,飲食隨意,工作權益得不到保護,甚至還要被沒收護照,控制行蹤……
越多的真相被揭露,新加坡客工在這一繁華國度中的低微地位就越赤裸地展示在人前,成爲新加坡最魔幻的現實之一。
衆所周知,新加坡是一個開放型國家,之所以能取得今天的發展成就,離不開其開放的環境。
然而,疫情爆發,全球化逆行,新加坡的兩大支柱産業:旅遊業和航空業損失重大,而且“封城”期間,幾乎所有門店關門,各行各業都陷入了停滯。
新加坡政府爲了維持社會的基本運轉,先後多次巨額財政撥款進行補貼和救濟。
但是經濟和生産生活情況遠沒有恢複正常,航空業旅遊業持續受挫,餐飲和零售業者也難以爲繼。
據統計,2020年第一季度,新加坡的國內生産總值(GDP)與上一季度相比下降了10.60%。
2020年第二季度,新加坡的國內生産總值(GDP)與上一季度相比下降了12.6%;環比去年第二季度,經濟萎縮41.2%。 連續兩個季度的經濟萎縮意味著新加坡經濟正式陷入技術性衰退。
這樣的情況下,爲了保護本地人就業,新加坡政府采取了一系列在外國人看來異常“魔幻”的操作: 一年內三次提高外國准最低薪資門檻;縮減SP發放配額……一套組合拳打得外國人猝不及防。 這波操作下來,強行魔幻,人爲魔幻,牆都不扶,就服新加坡。
以上可以都看作是疫情帶來的連鎖反應。
但新加坡今年的“史無前例”事件還有一件事跟疫情沒啥關系的,那就是史上最嚴重的登革熱。
根據新華社報道,截至10月12日,新加坡2020年以來已有28人因患登革熱死亡,該病累計確診病例數突破31400例,這兩項數據均超過往年最高紀錄。
而且,新加坡今年的登革熱死亡病例與新冠死亡病例數基本相仿,情勢不容樂觀。
登革熱是由登革熱病毒引起的急性傳染病,主要通過蚊蟲叮咬在人群中傳播。
新加坡城市環境整潔幹淨,一般是室外蚊蟲更多,而今年有那麽多人長時間待在家裏,卻還創造了年度登革熱確診和死亡新高,看來新加坡是真的魔幻了。
02.
中國的魔幻2020
如果一定要爲2020年的魔幻定一個開頭,新冠疫情在中國武漢的大規模爆發無疑會成爲最強有力的候選之一。
大概從來都沒有人會想過,武漢這座城市會以這樣一種方式吸引全世界的目光。
千萬級人口的城市,一紙令下,封城!
本應熱鬧繁華的中國春節,卻變成了人人居家不出的情況。
魔幻的行爲就此出現:
封城前,500萬人“逃離”了武漢;之後,更有不計其數的人“談鄂色變”。
這500萬人裏,有在武漢工作,例行回家過年的外地人;有疫情開始之前,在外旅行工作的人;有封城前夜,攜全家老小驅車離開武漢的人。
他們或許無心,或許有意,但無論如何,不服從指揮的這500萬人,多少增加了疫情在全國擴散的風險。
某些人的“逃離”行爲被曝光之後,大家把對病毒的恐懼,轉移到所有在武漢有居住史的人身上,以致到了“談鄂色變”的地步。
于是,武漢籍學生被舉報,鄂A車牌號的汽車被砸爛……不可謂不魔幻。
4月之後,武漢迎來解封,國內各地區疫情逐步得到良好控制,人民的生産生活逐漸恢複到以往的狀況。
這個時候,魔幻的“黑人擡棺”火遍了大江南北。
這是一段視頻,來自BBC,視頻中7個黑人分成兩排,西裝革履,帶著禮帽,擡著一具華麗的棺材蹦迪。
據介紹,這種擡棺舞是加納人的一種習俗,當地人會雇傭專業的擡棺隊用這種歡快的形式送別親人。這種用喜劇形式告別死亡的方式,被中國網友戲稱爲“專業團隊”。 “黑哥一笑,生死難料。棺材一擡,世間白來”。 在4月初武漢解封之後,面對疫情帶來的生離死別,這一則視頻讓很多人笑中帶淚,也許死亡並是非生命的終結,而是新的開始。
或許疫情給人們帶來的傷痛確實需要這樣的樂觀與撫慰。 同時,受疫情影響的中國經濟也迎來了新的魔幻救星。 其實,經濟受到疫情沖擊在全球都是常態,大部分國家往往會選擇和新加坡類似的方式,發放補貼,鼓勵生産。 在中國,火的卻是在過去20年間淡出人們視線已久的“地攤”。
2020年新冠疫情高峰過去後的中國兩會,總理李克強先是在兩會回答記者提問期間指出:中國是一個人口衆多的發展中國家,人均年收入是3萬元人民幣。
“但是有6億人每個月的收入也就1000元。1000元在一個中等城市可能租房都困難,現在又碰到疫情,疫情過後民生爲要。”
沒過幾天,李克強總理在山東煙台考察時表示:
“地攤經濟、小店經濟是就業崗位的重要來源,是人間的煙火,和’高大上’一樣,是中國的生機。”
總理親自“站台”,地攤還能不火?
隨著中國總理李克強一句它”是人間的煙火”,是”中國的生機”。
“地攤經濟”如今成爲了中國各地政府恢複就業的政策法寶,和世界上其他各國的經濟恢複政策來說,這也算得上是個魔幻救星了。
內部“地攤經濟”發展的如火如荼,中國的出海企業卻遭到了美國及其盟友來自各個角度的圍堵。
美國對華爲、TikTok、抖音下達封殺令;
英國下令禁用華爲5G技術;
印度也禁止了58款中國應用在該國的使用……
看著中國這些代表性企業在全球範圍內遭到針對,特朗普的手段簡單而又粗暴,帶著毫不遮掩的目的性,無懼人言,當真魔幻。
10月,“打工人”成爲熱門詞彙。
“打工你會少活十年,不打工你一天都活不下去,早安,打工人!” 一時間,全網都刷滿了打工人語錄。“打工人”們往往起早貪黑,拿著微薄的工資,但工作卻十分辛苦。
當大家紛紛自嘲打工人的時候,這種態度某種程度上確實是一種自我輕賤,但某種程度上,這又是一種自我保護,甚至是牟利。
這個詞語,跟“社畜”的性質類似,卻又比“社畜”多了一分自我調侃。
這些“打工人”沒有跟老板拍桌子的勇氣,也沒那份沖動;對這個社會有一些不滿,卻也無力改變……
想一想,社會已經如此魔幻,多些“打工人”的樂觀精神,倒也未必不是件好事。
03.
世界的魔幻2020 2020年是新加坡的,是中國的,更是世界的。 超級蝗災肆虐亞非多國、澳洲山火持續燃燒7個月、青藏高原發現28種新病毒、北極甲烷爆發、南極高溫血紅一片…… 這一系列的災難和反常現象,格外觸目驚心,簡直就像有人打開了潘多拉的盒子。
這讓人想起來流浪地球的台詞:
“最初,沒有人在意這場災難,這不過是一場山火,一次旱災,一個物種的滅絕,一座城市的消失。直到這場災難和每個人息息相關。”
歸結起來,2020年的魔幻世界體現在四個方面:
病毒,氣候,局勢與告別。
病毒,就不用說了,新冠疫情在全世界範圍內肆虐。
截至12月2日,全球新冠確診病例數超6446萬,死亡人數超149萬,觸目驚心。
其中,超級大國美國以超1391萬確診病例數與超27萬死亡人數名列世界第一。但是這個世界第一,相信美國也並不想要。
6月,新冠病毒在全球“風頭正勁”的當下,非洲的埃博拉病毒卷土重來了。
這已經是剛果爆發的第11輪埃博拉疫情,而當地兩年前爆發的第10次埃博拉疫情,至今尚未結束。
在非洲境內,埃博拉病毒已經肆虐多年,是像死神一般的存在,奪取了無數人的生命。它的致死率在50%至90%之間,是迄今發現的致死率最高的病毒之一。 患者感染埃博拉病毒後所表現的症狀,極其可怕。 最開始是發燒、惡心、腹瀉;用不了幾天就會周身疼痛,七竅流血不止;再嚴重一點,髒器的碎片會隨著血水不斷被患者嘔出,全身布滿出血的孔洞;最後,患者死亡。因爲體內器官都已經報廢。這個過程非常短,從被感染至死亡,僅僅只需要1-2周時間。
根據新華社報道,截至8月22日,短短兩個月時間裏,埃博拉病毒已經有96例確診,43例死亡。 好在11月18日,持續六個月的這一輪埃博拉疫情終于宣告。 在這一輪疫情中,確診病例達119例,疑似病例11例,死亡55人。
而在11月16日,也就是剛果第十一輪埃博拉疫情宣告結束的前兩天,美國熱帶醫學與衛生學會(ASTMH)會議上,研究人員提出,在玻利維亞發現的致命病毒—— 查帕雷病毒(Chapare virus)已在醫療機構中發生人際傳播。 這是一種沙粒病毒(arenaviruses),該分類還包含拉沙病毒(Lassa virus),其引發的拉沙熱在西非每年導致數千人死亡。
查帕雷病毒感染會引發出血熱,症狀與埃博拉相似,目前證據顯示它可能通過體液傳播。
最早關于查帕雷病毒感染的記錄是在 2004 年,玻利維亞查帕雷省出現了一個確診病例。
此後在 2019 年,該病毒在玻利維亞首都拉巴斯(La Paz)造成了至少 5 例感染,2 名患者將病毒傳播給了 3 名醫護人員,一共 3 人死亡。
這些還只是一些致死率較高或是蔓延規模較大的病毒。
目前科學家在全球範圍內發現了大約6000多種不同的病毒,但有人認爲這只是冰山一角。人類和病毒的鬥爭,還將是一條漫長的道路。
美國俄亥俄州立大學的一個研究團隊,年初在青藏高原的冰核樣本中發現了古老病毒存在的證據。
在33種不同病毒的遺傳信息中,科學家發現有28種是全新的,人類未曾發現和描述過它們,這意味著它們可能已經在冰層中存在了數萬年之久。
全球變暖會導致冰川融化速度加快,冰川的融化實際上並不僅僅是讓海平面上升那麽簡單,它可能會釋放出曾經冰封下的古老病毒。 這就引出了2020魔幻世界的第二彈:氣候。
當全世界仍將目光聚焦在新冠疫情上時,很少有人意識到,全球氣候變化所引發的種種次生災難,正把人類世界拖入另一個泥潭。
2015年至2019年,是人類有記錄以來最熱的5年,而接下來十年中的每一年,都可能會進入地球史上最熱十年的排行榜。
2020年,就連冰雪皚皚的北極,都在刷新“高燒”紀錄。
北極圈內的俄羅斯維爾霍揚斯克小鎮,是北半球的寒極之一,又被稱爲“和火星一樣冷的地方”。然而,6月20日,這裏的氣溫竟然逼近38℃,刷新了北極圈內有記錄以來的最高溫度紀錄。
沒有最熱,只有更熱。
高溫天氣還爲森林火災的肆虐創造了絕佳條件。而森林生態系統,又是地球上物種最豐富的生態系統。
因此,森林大火所造成的影響也遠超想像。
世界自然基金會(WWF)曾發布一份令人揪心的報告:從2019年一直持續到2020年的澳大利亞山火,已燒焦了約一個英國大小面積的土地。
大火還造成生活在那裏的約30億只動物,包括24.6億爬蟲、1.8億鳥類、1.43億哺乳動物,和5100多萬只蛙類,死亡或流離失所。
澳洲的這場大火還往大氣中釋放了足足4億噸的二氧化碳。
4億噸意味著什麽?這已經是全球116個二氧化碳排放量最低的國家一年排放量的總和。也就是說,澳洲這把火,讓世界各國努力減排幾年的成果全都白費了。
2月9日,在山火肆虐數月後,一場持續四天的大雨緩解了火勢。
這也是澳大利亞首都雪梨及周邊地區30年來最大規模的一場持續降雨。但是,連續幾天強降雨卻又帶來了洪災……
而在南美洲,2019年曾吸引了全世界目光的亞馬遜雨林大火,在2020年也卷土重來。
巴西國家太空研究所表示,2020年7月,亞馬遜雨林的火災數量高達6803起,同比增長了28%。
不僅是林火,人類的砍伐活動也在加劇亞馬遜雨林生態的惡化。
對亞馬遜溫室氣體的一項研究顯示,經過砍伐,多達五分之一的亞馬遜雨林目前排放的二氧化碳比吸收的還要多。
科學家擔心,如果依照目前的速度,亞馬遜雨林失去“地球之肺”稱號的速度會比預期更快。
再說說東非的蝗災。
今年造成巨大威脅的蝗災,氣候變化正是幕後推手。
正因爲蝗災發源地阿拉伯半島的沙漠地帶遭遇了兩場久違的氣旋風暴和降雨,沙漠蝗蟲才得到了大肆繁殖的機會。
蝗災將使地區糧食安全和民衆生計面臨前所未有的威脅。
以埃塞俄比亞爲例,糧農組織說,蝗蟲目前已在該國的160多個地區大量繁殖,破壞了近20萬公頃耕地,100多萬人因此陷入糧食不安全境地。
世界局勢方面,在今年也是動蕩得緊。
1月3日,美國啓用無人機在伊拉克空襲殺死伊朗最高革命領袖西姆·蘇萊曼尼,爲今年的世界局勢給出了一個動蕩的開局。
1月8日,由德黑蘭起飛的烏克蘭民用客機被伊朗軍方“意外炸毀”,機內176人無一生還。
空襲、戰爭、導彈襲擊客機。本在和平年代不該發生的事情,發生了。
處于“動蕩”中心的美國,面對著“美伊關系緊張”“中美關系緊張”等等局面,自己還碰上了史上“最難産”的大選。
進入20世紀後,由于通訊技術的進步,美國大選一般當天晚上或第二天早上媒體就宣布結果。
然後敗北的候選人向勝利者道賀,各國領導人紛紛致電祝賀新當選總統,總統交接工作立馬展開,曆史翻過一頁。
今年美國大選,情況特殊。
除了大量郵寄選票導致當天計票不能完成外,還有一個拒絕被曆史翻頁的特殊總統——特朗普。
直到11月8日,CNN和美聯社宣布:拜登贏了美國大選。
當美國媒體報道民主黨候選人拜登勝選的消息時,特朗普正在維吉尼亞州打高爾夫球。
他立即發聲明回應,指這場選舉還未結束,拜登就急于假扮成勝利者。
特朗普在聲明中稱,
“我們都知道爲什麽喬·拜登正急于假裝成贏家,爲什麽他的媒體盟友正努力幫助他:他們不希望真相被揭露出來。簡單的事實就是,這場選舉還遠遠沒有結束。”
此後,特朗普拒絕承認大選結果,瘋狂發推,提出法律訴訟……
當地時間11月29日,特朗普接受了福克斯新聞主播瑪麗亞·巴蒂羅莫(Maria Bartiromo)的采訪。
他表示,不會向對手拜登認輸,也不會改變對選舉出現大規模舞弊現象的看法;並堅持,即使六個月後,他也不會改變選舉舞弊的說法。
法新社稱,特朗普還抱怨司法部和聯邦調查局沒有向他提供幫助。
而當被問及他的團隊何時將終止法律訴訟時,他說:“我不會說出一個日期。”
這場大選或許永遠不會在特朗普的心中落幕了。
年末,美伊問題似乎還嫌開年造成的動蕩不夠。
據美國《紐約時報》11月27日報道,在伊朗頂級核科學家被暗殺數小時後,伊朗強硬派抗議者舉行示威活動,高呼口號:
“不向美國屈服,不向美國讓步,只向美國開戰!”
魔幻2020的世界局勢,由誰開頭,就由誰收尾。
2020年,對世界來說,還是告別的一年。
1月26日,NBA傳奇巨星科比布萊恩特乘坐直升飛機從加州橙郡飛往位于洛杉矶北部的曼巴學院之時,突然遭遇到直升機意外墜毀事故不幸去世,享年41歲。
在科比去世那天,足壇巨星馬拉多納在自己的社交媒體發文悼念,配上一張帶有翅膀的科比的照片:
“科比, 我在布宜諾斯艾利斯見過你。祝你一切都好。也爲科比的女兒以及同乘人員趕到遺憾。再見,傳奇。”
馬拉多納還曾說過,科比和自己一樣偉大。
在時隔304天後,馬拉多納在家中因心髒驟停,搶救無效去世。
10年前,科比曾說,自己曾經幻想成爲馬拉多納。
在2010年南非世界杯,科比曾親臨現場觀戰美國對加納的16強比賽,他在接受采訪時曾說,籃球並不是他的全部。
“當我還是個孩子的時候,我就愛上足球這項運動了,那時候我生活在意大利,並且是AC米蘭球迷,夢想著有朝一日我能成爲馬拉多納、範巴斯滕、羅伯特巴齊奧那樣的球員,這是我無法忘記的回憶。”
如今,魔幻的2020年帶走了他們,體壇兩大巨星可以相約在天堂。
再過不到一個月,我們就要與魔幻的2020年說再見了。 很多人都在感歎,今年是最難的一年,這不是錯覺。我們就像大江大河中的小小扁舟,在時代洶湧的洪流裏誰也無法逃避。
《黃金時代》裏王小波曾這樣寫道:生活就是個緩慢受錘的過程。
想想我們,都是如此在充滿魔幻的現實中過著緩慢受錘的日子。
終于,2020年將要過去,在惋惜時間太快的同時,不由地小松了口氣。
願一切災難都隨時間遠去,願人們齊心協力挺過一次次的災難,變得更加強大。
再見,2020年。
一起期待即將到來的2021年。
⊙文章版權歸“SingPlus新加坡直通車”所有,盜用將承擔法律責任,轉載請聯系後台。資料來源:
1. 鳳凰網財經:鄭永年:這次疫情沖擊,有3個“史無前例”
2. 騰訊網:青藏高原發現28種新病毒,已存在數萬年,全球變暖的新弊端出現!
3. 科研圈:又一種致命病毒出現人際傳播,症狀與埃博拉類似
4. 聯合國新聞:聯合國機構歡迎剛果(金)西部埃博拉疫情宣告結束
5. 新西蘭中文先驅網:“魔幻”2020:除了新冠疫情,還有這些氣候災難愈演愈烈……
6. 金融紫禁城:“向美國開戰!!!”伊朗遭“ 突然襲擊 ”!戰爭爆發了!!
7. BBC中文:新加坡新冠疫情暴露出的不平等現象
8. 威學一百:魔幻2020,只剩最後30天啦!
-END- 點擊下圖,發現不一樣的新加坡
點亮在看,共同期待2021!